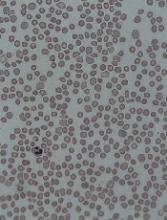

The US Food and Drug Administration (FDA) has approved avatrombopag (DOPTELET®), a second-generation thrombopoietin receptor agonist.
Avatrombopag is now approved to treat thrombocytopenia in adults with chronic liver disease (CLD) who are scheduled to undergo a procedure.
Dova Pharmaceuticals, Inc., plans to launch the drug in June.
The FDA approved avatrombopag based on data from 2 randomized, double-blind, placebo-controlled phase 3 trials—ADAPT-1 (n=231) and ADAPT-2 (n=204).
The trials enrolled adults with thrombocytopenia (platelet count less than 50,000/µL) and CLD.
Patients received 40 mg or 60 mg of avatrombopag daily for 5 days based on their baseline platelet counts (40 to <50,000/mL or <40,000/mL, respectively), or they received placebo.
In both trials, avatrombopag reduced the need for platelet transfusions or rescue procedures for bleeding up to 7 days following a scheduled procedure.
In ADAPT-1, platelet transfusions/rescue procedures were not required for:
- 66% of patients in the 60 mg avatrombopag arm and 23% of matching placebo recipients (P<0.0001)
- 88% of the 40 mg avatrombopag arm and 38% of matching placebo recipients (P<0.0001).
In ADAPT-2, platelet transfusions/rescue procedures were not required for:
- 69% of patients in the 60 mg avatrombopag arm and 35% of matching placebo recipients (P=0.0006)
- 88% of the 40 mg avatrombopag arm and 33% of placebo recipients (P<0.0001).
The most common adverse events (AEs) in both trials (in the avatrombopag and placebo groups, respectively) were pyrexia (10% and 9%), abdominal pain (7% and 6%), nausea (7% for both), headache (6% for both), fatigue (4% and 3%), and peripheral edema (3% and 2%).
The incidence of serious AEs was 7% in the 60 mg avatrombopag group and 13% in the matching placebo group. The incidence was 8% in the 40 mg avatrombopag group and 3% in the matching placebo group.
The most common serious AE reported with avatrombopag was hyponatremia, occurring in 2 patients (0.7%).
AEs resulting in discontinuation of avatrombopag were anemia, pyrexia, and myalgia. Each of these events was reported in a single (0.4%) patient in the avatrombopag 60 mg group.
Additional data from ADAPT-1 and ADAPT-2 are available in the prescribing information for avatrombopag, which can be found at www.doptelet.com.